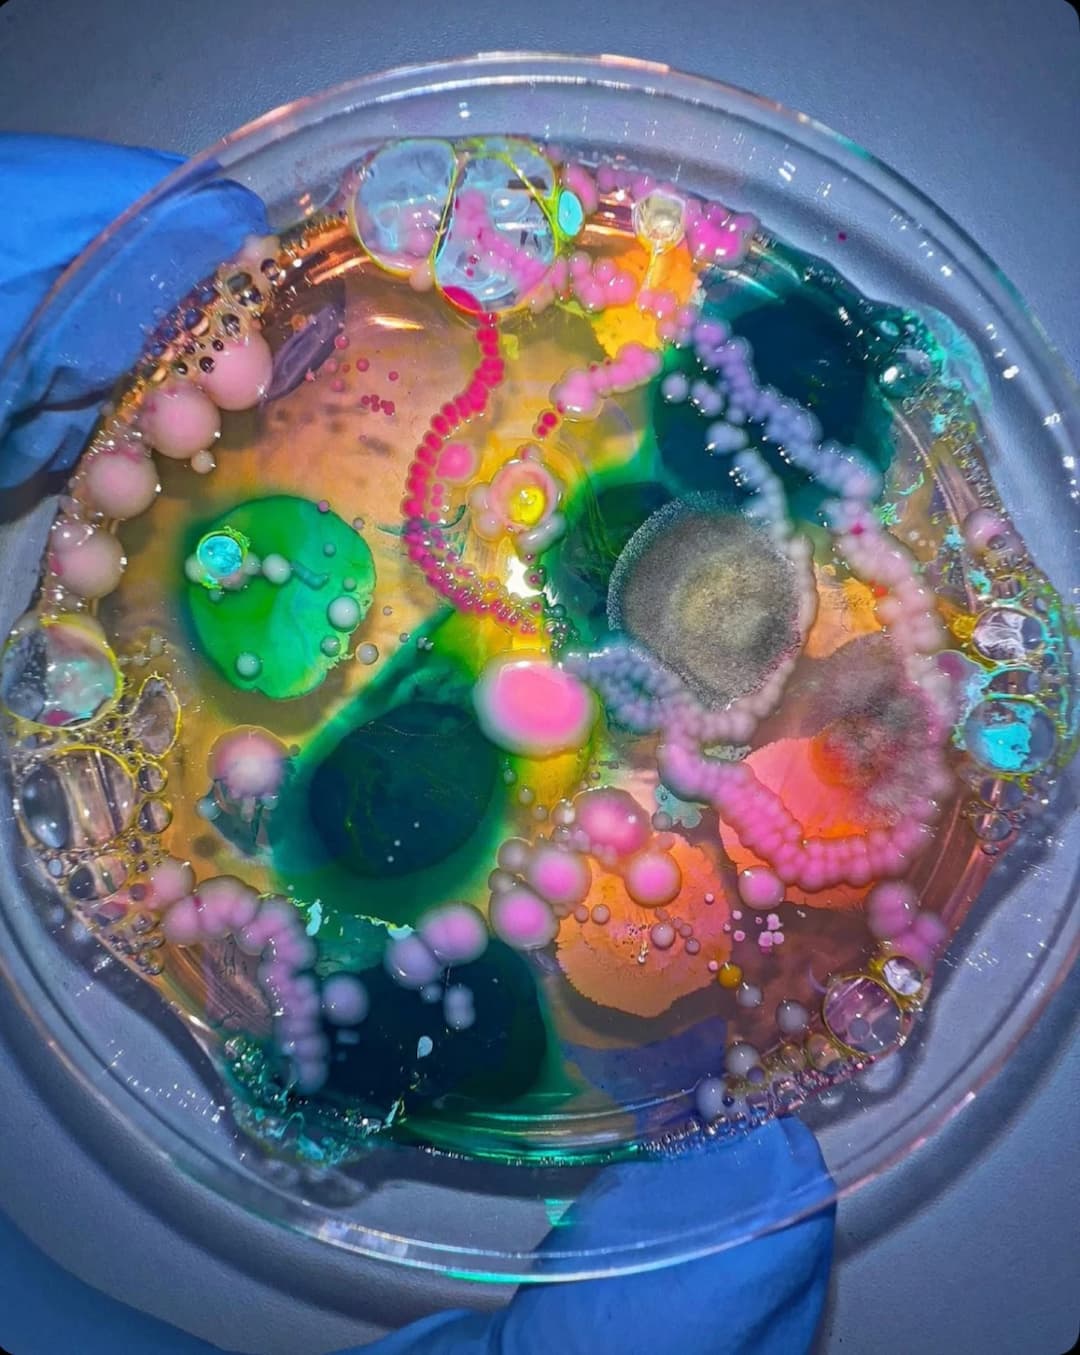
Beginner Course

Get Free Bio Resources & Tutoring!
Empowering young minds, fostering passion for biology.
biobridge.initiatives@gmail.com
Online Tutoring
+1 (917) 528-3875
Empowering Students in Biology
Unlock Your Potential with Bio Bridge Inc
Our Courses
Beginner Course
Our Beginner course is designed to introduce middle schoolers to the fascinating world of biology with engaging content and hands-on learning activities.

Intermediate Course
The Intermediate course caters to high school students preparing for the AP Biology test, offering targeted tutoring and personalized support to ace the exam.

USABO Boot Camp
Join our intensive USABO Biology Competition Boot Camp to enhance your skills, sharpen your knowledge, and excel in national-level biology competitions.
What we stand for?
BioBridge is a registered 501(c)(3) nonprofit; meaning we operate entirely for public benefit rather than profit. This status is important because it allows us to direct every dollar and resource toward supporting students, ensures accountability and transparency in how we operate, and makes contributions tax-deductible, encouraging community and donor support. At Bio Bridge Inc, we stand for empowering students with access to free resources and personalized tutoring in biology to help them excel in their academics and career aspirations.